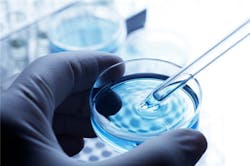
Smarter Cold Chains Needed for Life Sciences Smarter Cold Chains Needed for Life Sciences

Global demand for expensive structurally complex and temperature-sensitive biologics and specialty drugs is up. In fact it is expected to fuel approximately 60% growth for temperature controlled logistics to $13.4 billion by 2020.
This major increase requires a new generation of cold chains to be developed according to new research by DHL Global Forwarding.
“Astounding developments in the life sciences industry coupled with globalization means there is an opportunity for better health, pain relief and cure from disease for many millions of people around the world,” said Frank Appel, CEO of Deutsche Post DHL Group. “But getting the medication to patients in the right condition and achieving that goal requires a complex balancing of cost and risk. It emphasizes yet again the strong link between trade, logistics and the impact it has on improving people´s lives.”
Demand is the U.S is strong with spending expected to quadruple to $401.7 billion in 5 years, according to PricewaterhouseCoopers, with similar growth rates being projected for the rest of the world. This increase demand is particularly strong in emerging markets. World Economic Forum estimates that by 2020 one third of all global health expenditure will be in emerging markets.
These highly sensitive pharmaceuticals bring new complexity to the supply chain since they have specific condition tolerances and a high value. Annual per-patient treatment costs can be up to and above $100,000, making a single consignment worth up to $50 million.
“Collapsed cold chains due to non-appropriate conditions can result in loss of a shipment worth hundreds of thousands of dollars,”“ said Angelos Orfanos, president Life Sciences & Healthcare, DHL Customer Solutions & Innovation.
“Over the longer term, this can lead to a damaged reputation, slumping sales, potential share value and even pose a risk to patients. These are high stakes and a smarter supply chain is necessary to overcome these challenges. As the life sciences and healthcare industry expands and transforms to meet the growing needs of the world, logistics providers need specialist investment in research and development as well to be able to offer the expertise needed to get medicine and equipment to the patients. In the simplest terms: better logistics can contribute to better healthcare.”
According to the report, smarter cold chains must be consistent and robust, incorporating ways of mitigating risk and loss, with strong contingency capabilities and proactive problem-resolution processes. Most importantly, they must be built on four key essentials:
- A highly specialized and compliant network tuned to moving products efficiently, while protecting their integrity
- Globally consistent processes – policies and procedures that mitigate risk
- Risk-appropriate packaging – technology, cost appropriate, perfect handling
- Total cost strategy – includes assessing risk and the real cost of failure to the company
On their way to the “next-generation” cold chain, pharmaceutical companies should implement a third essential into their supply chain, the report says. This tackles packaging and finding the right balance between costs and risk. Today, shippers can choose between passive and active solutions. When making their decision though, manufacturers must consider a wide range of factors, such as the value of the product, its temperature-management needs, regulatory compliance requirements, customer and market risk, as well as total cost.
Finally, the fourth essential of a smarter supply chain is better cost management. According to the study, quite often, companies base their supply chain decisions on the direct costs visible to them, e.g. transportation or packaging costs. However, that’s just the tip of the iceberg. Potential indirect costs such as product losses, brand risks and regulatory issues are usually not accounted for due to the different siloes in an organization.